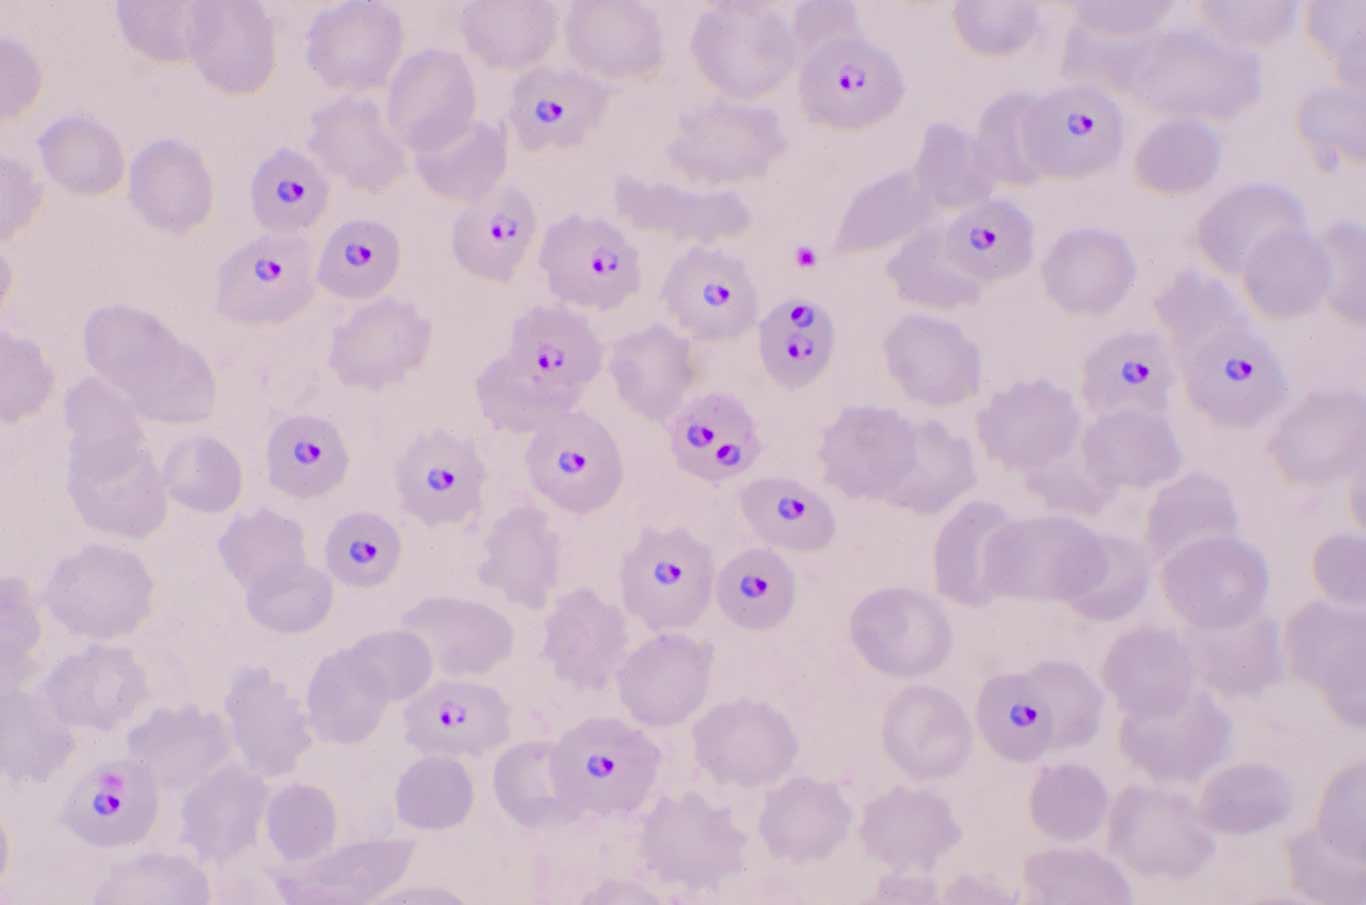

Programmes
Five programmes to advance every dimension of global health
Research Hubs
Our transversal hubs connect teams, ideas, and disciplines to foster knowledge exchange and joint solutions in critical areas
The Exposome Hub partnered with CSIC, the University of Barcelona and EMBL to organise the first Barcelona Exposome Symposium, featuring invited talks, abstract presentations and posters that showcased exposome research in the region and identified key community needs. In partnership with Utrecht University, it launched a large EC-funded initiative to build an International Human Exposome Network, aimed at integrating exposome research into public health and policy.
The Implementation Science Hub organised the Implementation Science module at ISGlobal’s Summer School, which once again had the highest number of students, and conducted a seminar for the Master of Global Health. It also delivered a lecture on the topic at the IPHASA Meeting in Uganda, and is currently developing a new Community of Practice (CoP) model, bringing together all of its partners.
The Health Analytics Hub was introduced in June with the creation of its distribution list. In September it collaborated with the UPF in the organisation of the Women in Data Science Worldwide event.
The Preparedness Hub strengthened alliances within and beyond Europe, co-organising a transatlantic policy dialogue in Berlin, and participating in a scientific session on pandemic preparedness with Barcelona’s Public Health Agency. It also launched P3R3 Global, a research and translation platform for health system resilience. Additionally, it published three policy briefs on the pandemic agreement, global preparedness, and adaptation to extreme weather events.
The Science with Society Hub was officially launched in November, though it was active throughout the year. It hosted the UNESCO Chair Knowledge 4 Change (K4C) residency; ran an internal training on participatory research as well as an online course for ISGlobal’s Spring School; and hired a postdoctoral researcher to support activities. It also finalised its schedule for 2025, featuring six bi-monthly meetings open to ISGlobal staff and students interested in participatory research.